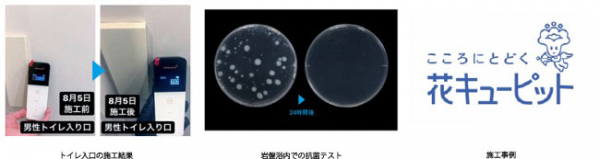

株式会社DAEG(ダエグ)(東京都港区、代表取締役:梅村圭司 以下、「ダエグ」という)は、あいおいニッセイ同和損保が提供する新型コロナウイルスや感染症に対応した「新型コロナウイルス感染症対策費用補償」を光触媒コーティングサービス「ナノチタニア(※2)」に自動付帯し、2021年5月1日より提供を開始致します。
サービス付帯型の補償で、従業員に新型コロナウイルス感染症を含む指定感染症の罹患者が発生し、保健所などから消毒・隔離などの措置が講じられた場合に、パーテーションやアクリル板の設置、罹患者以外の従業員のPCR検査費用など自社のブランドを守る対策を講じるための出費を補填するために保険金が支払われます。新型コロナウイルス感染症に対応したこのような補償は日本初(※1)となります
また、ダエグはナノチタニアを施工した店舗などで従業員が新型コロナウイルスに感染し保健所などの指示で休業を余儀なくされた場合に、休業損害を補償する保険を提案する体制を準備しています。
お客さまにとってはナノチタニアの施工により新型コロナウイルス感染症の拡大を未然に防止し、万一感染症に罹患した従業員が出てしまった場合には施設の消毒などによりブランドイメージの回復を図り、さらに施設が休業して実際に発生する粗利の損失の補償まで備えておくことで、一層の安全と安心をお客さまに提供できることを期待しています。
※1 当社調べによる
※2 ナノチタニアは光触媒コーティングサービス分野で株式会社DAEGにより商標登録出願中です。
■光触媒コーティングサービス「ナノチタニア」
光触媒とは、太陽光、蛍光灯、LEDなどの光を受けて強力な酸化力を生み、接触してくる有機物や細菌などの有機物質を除去する環境浄化物質のことで、代表として酸化チタンが広く知られています。ナノチタニアの表面で酸素と光子が反応し、原子状活性酸素となり、有機物・細菌・ウイルスなどに対して原子レベルで、これらを分解・破壊します。また、バインダー(のり)を使用しないため、バインダーの劣化とともに剥離することがなく、長期間持続します。
ナノチタニアは、独自の技術により、酸化チタン分子を素粒子(2nm以下) にまで分解し、水中に安定分散させた無色透明のチタン素粒子分散液です。
・酸化チタン分散液は無色透明であることで光触媒機能を持続させ、施工面の美観・質感を損わずに施工することができます。
・粒子2nm以下のチタン素粒子は表面上の原子に自己結合するため、バインダー(接着剤・のり)を使用して定着させる必要がありません。
サービス付帯型の補償で、従業員に新型コロナウイルス感染症を含む指定感染症の罹患者が発生し、保健所などから消毒・隔離などの措置が講じられた場合に、パーテーションやアクリル板の設置、罹患者以外の従業員のPCR検査費用など自社のブランドを守る対策を講じるための出費を補填するために保険金が支払われます。新型コロナウイルス感染症に対応したこのような補償は日本初(※1)となります
また、ダエグはナノチタニアを施工した店舗などで従業員が新型コロナウイルスに感染し保健所などの指示で休業を余儀なくされた場合に、休業損害を補償する保険を提案する体制を準備しています。
お客さまにとってはナノチタニアの施工により新型コロナウイルス感染症の拡大を未然に防止し、万一感染症に罹患した従業員が出てしまった場合には施設の消毒などによりブランドイメージの回復を図り、さらに施設が休業して実際に発生する粗利の損失の補償まで備えておくことで、一層の安全と安心をお客さまに提供できることを期待しています。
※1 当社調べによる
※2 ナノチタニアは光触媒コーティングサービス分野で株式会社DAEGにより商標登録出願中です。
■光触媒コーティングサービス「ナノチタニア」
光触媒とは、太陽光、蛍光灯、LEDなどの光を受けて強力な酸化力を生み、接触してくる有機物や細菌などの有機物質を除去する環境浄化物質のことで、代表として酸化チタンが広く知られています。ナノチタニアの表面で酸素と光子が反応し、原子状活性酸素となり、有機物・細菌・ウイルスなどに対して原子レベルで、これらを分解・破壊します。また、バインダー(のり)を使用しないため、バインダーの劣化とともに剥離することがなく、長期間持続します。
ナノチタニアは、独自の技術により、酸化チタン分子を素粒子(2nm以下) にまで分解し、水中に安定分散させた無色透明のチタン素粒子分散液です。
・酸化チタン分散液は無色透明であることで光触媒機能を持続させ、施工面の美観・質感を損わずに施工することができます。
・粒子2nm以下のチタン素粒子は表面上の原子に自己結合するため、バインダー(接着剤・のり)を使用して定着させる必要がありません。

■効果に関して
キッコーマン社ルミテスターSmartを使用した、ATP+ADP+AMPふき取り検査(A3法)※によるATP濃度チェック※A3法はキッコーマンバイケミファ独自の測定法でATP(アデノシン三リン酸)を汚染指標にして、ATPだけでなく、ADP,AMPも測定位することでより高感度の測定が可能な方法です。 ATPはあらゆる生物がもつ物質であり、食品や菌をはじめとした「有機物」の多くに共通して存在しています。 ATPが多ければ洗浄不足( =汚れが多い状態)であることがわかります。
岩盤浴内でナノチタニア施工前と施工後に同じ場所に接地させ、24時間常温放置後、培地内の状況を観察。(FoodStamp寒天培地使用)施工前の培地には、大腸菌のコロニーが散見されるが、ナノチタニア施工後の培地は殆ど変化が見られない。
ナノチタニアを施工することにより、施工面の抗菌力がアップし、菌の増殖を防いでいることが証明されている。3ヶ月間の継続観察によるデータでも同様に、施工面の菌の発生を防いでいることが確認されている。
■施工実績
花キューピット株式会社様
施工床面積:1948.6平米
<導入のコメント>
執行役員 営業事業本部 CS推進事業部長 滝沢 秀平 様
弊社は自社内でカスタマーセンターを運営しています。
常時40名程のオペレーターが勤務しており、三密を避けるため換気をしながら席間を空ける減席とテレワークの実施、アクリル板の設置等の対策を講じていますが、今般更に従業員に安心して安全に働いてもらえるよう本サービスを導入し万全を期しています。
これまでの施策に加えて今回ナノチタニアを導入したのは、効果が持続することと、商品として画期的な「仮に感染者が出た場合の消毒費用などが支払われる」1年間適用の保険が付帯されていることが大きいです。
キッコーマン社ルミテスターSmartを使用した、ATP+ADP+AMPふき取り検査(A3法)※によるATP濃度チェック※A3法はキッコーマンバイケミファ独自の測定法でATP(アデノシン三リン酸)を汚染指標にして、ATPだけでなく、ADP,AMPも測定位することでより高感度の測定が可能な方法です。 ATPはあらゆる生物がもつ物質であり、食品や菌をはじめとした「有機物」の多くに共通して存在しています。 ATPが多ければ洗浄不足( =汚れが多い状態)であることがわかります。
岩盤浴内でナノチタニア施工前と施工後に同じ場所に接地させ、24時間常温放置後、培地内の状況を観察。(FoodStamp寒天培地使用)施工前の培地には、大腸菌のコロニーが散見されるが、ナノチタニア施工後の培地は殆ど変化が見られない。
ナノチタニアを施工することにより、施工面の抗菌力がアップし、菌の増殖を防いでいることが証明されている。3ヶ月間の継続観察によるデータでも同様に、施工面の菌の発生を防いでいることが確認されている。
■施工実績
花キューピット株式会社様
施工床面積:1948.6平米
<導入のコメント>
執行役員 営業事業本部 CS推進事業部長 滝沢 秀平 様
弊社は自社内でカスタマーセンターを運営しています。
常時40名程のオペレーターが勤務しており、三密を避けるため換気をしながら席間を空ける減席とテレワークの実施、アクリル板の設置等の対策を講じていますが、今般更に従業員に安心して安全に働いてもらえるよう本サービスを導入し万全を期しています。
これまでの施策に加えて今回ナノチタニアを導入したのは、効果が持続することと、商品として画期的な「仮に感染者が出た場合の消毒費用などが支払われる」1年間適用の保険が付帯されていることが大きいです。
■サービス料金
NanoTitania(ナノチタニア)は、サービス付帯型補償付き光触媒コーテイングサービスです。プランドイメージ費用・利益保険で、店舗やオフォスなどでの感染症リスクから企業や従業員を守ります。
NanoTitania(ナノチタニア)は、サービス付帯型補償付き光触媒コーテイングサービスです。プランドイメージ費用・利益保険で、店舗やオフォスなどでの感染症リスクから企業や従業員を守ります。

■新型コロナ感染症対策費用補償に関して
以下の条件をサービスに付帯して提供します。
以下の条件をサービスに付帯して提供します。

■代理店やフランチャイズ加盟店募集
ダエグは、次世代光触媒コーティングサービス「ナノチタニア」の正規代理店及びフランチャイズ加盟店を募集いたします。
【問い合わせ先】
株式会社DAEG 担当:長谷川 TEL:03-6811-1209
■会社概要
会社名 : 株式会社DAEG
所在地 : 東京都港区赤坂2丁目21-15 赤坂OSビル3F
代表取締役 : 梅村 圭司
設立 : 2004年4月22日
事業内容 : 感染症対策事業(光触媒コーティング、次亜塩素酸水噴霧器)
URL : コーポレートサイト http://www.daeg.co.jp
サービスサイト http://www.nano-titania.com
【報道問い合わせ先】
株式会社DAEG 担当:長谷川 TEL:03-6811-1209
ダエグは、次世代光触媒コーティングサービス「ナノチタニア」の正規代理店及びフランチャイズ加盟店を募集いたします。
【問い合わせ先】
株式会社DAEG 担当:長谷川 TEL:03-6811-1209
■会社概要
会社名 : 株式会社DAEG
所在地 : 東京都港区赤坂2丁目21-15 赤坂OSビル3F
代表取締役 : 梅村 圭司
設立 : 2004年4月22日
事業内容 : 感染症対策事業(光触媒コーティング、次亜塩素酸水噴霧器)
URL : コーポレートサイト http://www.daeg.co.jp
サービスサイト http://www.nano-titania.com
【報道問い合わせ先】
株式会社DAEG 担当:長谷川 TEL:03-6811-1209




